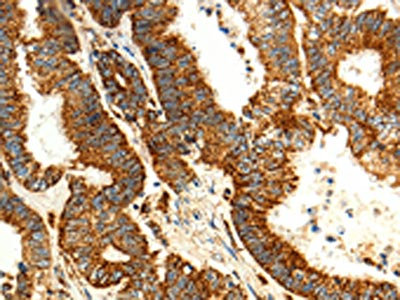

MAP1LC3A Antibody
-
中文名稱:MAP1LC3A兔多克隆抗體
-
貨號:CSB-PA578056
-
規(guī)格:¥1100
-
圖片:
-
The image on the left is immunohistochemistry of paraffin-embedded Human colon cancer tissue using CSB-PA578056(MAP1LC3A Antibody) at dilution 1/15, on the right is treated with fusion protein. (Original magnification: ×200)
-
The image on the left is immunohistochemistry of paraffin-embedded Human gastric cancer tissue using CSB-PA578056(MAP1LC3A Antibody) at dilution 1/15, on the right is treated with fusion protein. (Original magnification: ×200)
-
-
其他:
產(chǎn)品詳情
-
Uniprot No.:
-
基因名:MAP1LC3A
-
別名:ATG8E antibody; Autophagy related protein LC3 A antibody; Autophagy related ubiquitin like modifier LC3 A antibody; Autophagy-related protein LC3 A antibody; Autophagy-related ubiquitin-like modifier LC3 A antibody; LC3 antibody; LC3A antibody; MAP1 light chain 3 like protein 1 antibody; MAP1 light chain 3-like protein 1 antibody; MAP1A/1B light chain 3 A antibody; MAP1A/MAP1B LC3 A antibody; MAP1A/MAP1B light chain 3 A antibody; MAP1ALC3 antibody; MAP1BLC3 antibody; Map1lc3a antibody; Microtubule associated proteins 1A/1B light chain 3 antibody; Microtubule-associated protein 1 light chain 3 alpha antibody; Microtubule-associated proteins 1A and 1B, light chain 3 antibody; Microtubule-associated proteins 1A/1B light chain 3A antibody; MLP3A_HUMAN antibody
-
宿主:Rabbit
-
反應(yīng)種屬:Human,Mouse,Rat
-
免疫原:Fusion protein of Human MAP1LC3A
-
免疫原種屬:Homo sapiens (Human)
-
標(biāo)記方式:Non-conjugated
-
抗體亞型:IgG
-
純化方式:Antigen affinity purification
-
濃度:It differs from different batches. Please contact us to confirm it.
-
保存緩沖液:-20°C, pH7.4 PBS, 0.05% NaN3, 40% Glycerol
-
產(chǎn)品提供形式:Liquid
-
應(yīng)用范圍:ELISA,IHC
-
推薦稀釋比:
Application Recommended Dilution ELISA 1:2000-1:5000 IHC 1:25-1:100 -
Protocols:
-
儲存條件:Upon receipt, store at -20°C or -80°C. Avoid repeated freeze.
-
貨期:Basically, we can dispatch the products out in 1-3 working days after receiving your orders. Delivery time maybe differs from different purchasing way or location, please kindly consult your local distributors for specific delivery time.
-
用途:For Research Use Only. Not for use in diagnostic or therapeutic procedures.
相關(guān)產(chǎn)品
靶點詳情
-
功能:Ubiquitin-like modifier involved in formation of autophagosomal vacuoles (autophagosomes). While LC3s are involved in elongation of the phagophore membrane, the GABARAP/GATE-16 subfamily is essential for a later stage in autophagosome maturation. Through its interaction with the reticulophagy receptor TEX264, participates in the remodeling of subdomains of the endoplasmic reticulum into autophagosomes upon nutrient stress, which then fuse with lysosomes for endoplasmic reticulum turnover.
-
基因功能參考文獻(xiàn):
- Expression and Clinical Significance of LC-3 and P62 in Non-small Cell Lung Cancer PMID: 29945702
- High LC3 Expression is Associated with Cancer Progression and Chemo-Resistance in Esophageal Squamous Cell Carcinoma. PMID: 29022200
- Data suggest that, in patients with diabetic kidney disease, urinary excretion of mRNAs for MAP1LC3A, WIPI2, and RB1CC1 is down-regulated as compared to healthy control subjects; these transcripts may serve as urinary autophagy biomarkers. (MAP1LC3A = microtubule associated protein 1 light chain 3; WIPI2 = WD repeat domain phosphoinositide-interacting protein 2; RB1CC1 = RB1 inducible coiled-coil 1) PMID: 28760651
- Autophagy proteins were discovered on phagosomes engulfing foreign bacteria, leading to the proposal of LC3-associated phagocytosis (LAP). [review] PMID: 28755428
- data raise important issues regarding the interpretation of LC3 lipidation data and the use of autophagy modulators PMID: 28296541
- High LC3 expression is associated with endometriosis. PMID: 28348069
- Co-expression of FKBP8 with LC3A profoundly induces Parkin-independent mitophagy. Strikingly, even when acting as a mitophagy receptor, FKBP8 avoids degradation by escaping from mitochondria. In summary, this study identifies novel roles for FKBP8 and LC3A, which act together to induce mitophagy. PMID: 28381481
- we report that autophagy is associated with apoptosis processes, involving LC3 and TRIF-colocation in human HCC cells. Regulation of autophagy and the TLR3-TRIF pathway may be effective in the treatment of liver cancer. PMID: 27338037
- The autophagy induced by 2-PCPA requires LC3-II processing machinery..2-PCPA treatment induces the change of global gene expression program, including a series of autophagy-related genes, such as SQSTM1/p62. Taken together, our data indicate that KDM1A/LSD1 inhibitors induce autophagy through affecting the expression of autophagy-related genes and in a BECN1-independent manner PMID: 28800922
- LC3 and p62/SQSTM1 have roles in early-stage non-small cell lung cancer PMID: 27250032
- Hotspot mutations in the arginine-rich stretch in MAP1LC3A resulting in reduced cleavage of MAP1LC3A by ATG4B both in vitro and in vivo, suggesting a functional implication of this gene mutation in cancer development. PMID: 27256984
- analysis of soluble SQSTM1 complexes and soluble complexes formed between SQSTM1 oligomers and LC3 using a combination of fluorescence microscopy-based biophysical approaches in living cells PMID: 27442348
- we found that ATG14 interacted with Ulk1 and LC3, and knock down of Ulk1 prevented the lipidation of LC3 and autophagy in HeLa-ATG14 cells. We also identified a phosphatidylethanolamine (PE) binding region in ATG14, and the addition of Ulk1 to Hela-ATG14 cells decreased the ATG14-PE interaction. PMID: 28069524
- Legionella pneumophila RavZ extracts LC3-PE from the membrane before deconjugation. RavZ initially recognizes the LC3 molecule on membranes via its N-terminal LC3-interacting region (LIR) motif. PMID: 28395732
- The results are consistent with a model in which RPIA suppresses autophagy and LC3 processing by modulation of redox signaling. PMID: 27328773
- can act as a negative mediator in autophagy through stimulation of the AKT-MTORC1 pathway and direct interaction with LC3. PMID: 27540684
- Data show that p62 interaction with LC3, leading to the delivery of p62 and its cargoes to the autophagosome. PMID: 28740232
- LC3 puncta were still present in the granular layer of nonlesional psoriatic epidermis but at a much lower level compared with healthy adult epidermis, whereas in lesional psoriatic skin, LC3 was not expressed at all. PMID: 27021405
- Results suggest that P. gingivalis internalization is not necessary for LC3 lipidation. PMID: 26452236
- Although neither GABARAPs nor LC3s are required for autophagosome biogenesis, loss of all Atg8s yields smaller autophagosomes and a slowed initial rate of autophagosome formation. PMID: 27864321
- Methylation silencing of MAP1LC3Av1 promotes gastric carcinogenesis. PMID: 28214334
- Development of LC3/GABARAP sensors containing a LIR and a hydrophobic domain to monitor autophagy. PMID: 28320742
- Aldo was revealed to induce autophagy, as indicated by the increased conversion from microtubuleassociated protein 1A/1Blight chain 3 (LC3)I to LC3II, the increased expression levels of autophagyrelated gene 7 (Atg7) and the increased degradation of p62, which was accompanied by MC proliferation PMID: 27748808
- LC3 overexpression is associated with colorectal cancer. PMID: 27444698
- these findings were reversed with the LC3I/II-shPTEN treatment. Therefore, the loss of PTEN may promote the development of primary resistance to trastuzumab in breast cancer via autophagy defects PMID: 26563373
- autophagy of cytoplasmic bulk cargo was completely LC3 independent. PMID: 26237084
- Results of our present study demonstrated that beclin 1 and LC3 immunoreactivity increased in carcinoma cells following exemestane treatment and that the status of pre-treatment stromal beclin 1 is associated with higher carcinoma cell proliferation and poor clinical and pathological responses to NAE PMID: 26984766
- Consistent with the in vitro results, we observed that the expression of autophagy marker LC3 was increased. PMID: 26676801
- Up-regulation of LC3 is associated with carcinogenesis and progression of Salivary Adenoid Cystic Carcinoma. PMID: 26350055
- up-regulated expression during the monocyte-to-dendritic cell transition PMID: 26395023
- LC3 is exploited by coxsackievirus in both autophagy-dependent and -independent manners in vivo PMID: 26090585
- Autophagy status, as determined by combined LC3, Beclin 1 and p62 expression, might be independently associated with poor survival in patients with gastric cancer. PMID: 26722036
- Western blot and immunofluorescence validated antibody specificity, knockdown efficiency and autophagy induction prior to fixation in formalin and embedding in paraffin. LC3B and p62 antibodies were validated on cell pellets PMID: 26150155
- In colorectal cancer, differentiation degree and lymph node metastasis were associated with LC3 overexpression. LC3 expression was significantly higher in cancerous tissue than in adjacent tissue. PMID: 26097572
- high nuclear HMGB1 levels and cytoplasmic HMGB1 expression predicted poor overall survival (OS) and disease-free survival (DFS). Meanwhile, high LC3 expression was associated with favorable prognosis. PMID: 26084608
- These results demonstrate the essential role of BECN1 in the functional formation of autophagosomes, but not in LC3B lipidation. PMID: 25955014
- The authors show that LC3 is recruited specifically around secreting Shigella flexneri bacteria that are still present in vacuoles formed during entry and cell-to-cell spread. PMID: 26015503
- Downregulation of beta 3 -integrin with cRGD peptide resulted in enhanced LC3-II and Beclin-1 and decreased Bcl-2 expression. PMID: 25824726
- These data add novel mechanistic insights into the regulation of noncanonical LC3 lipidation and its associated processes, including LC3-associated phagocytosis. PMID: 25484071
- direct association with LC3 and p62 is promoted in osteoblasts by bioactive silica nanoparticles PMID: 24806912
- Results showed that detergent-insoluble LC3-I and -II levels were significantly higher in multiple system atrophy brain tissue than those in controls PMID: 22959883
- Clusterin facilitates stress-induced lipidation of LC3 and autophagosome biogenesis to enhance cancer cell survival. PMID: 25503391
- This study aimed to explore autophagy-related protein light chain 3 (LC3)-II expression levels in thyroid diseases. PMID: 25661375
- CHDH is required for PARK2-mediated mitophagy for the recruitment of SQSTM1 and LC3 onto the mitochondria for cargo recognition PMID: 25483962
- PLP2-TM interacts with the key autophagy regulators, LC3 and Beclin1, and promotes Beclin1 interaction with STING, the key regulator for antiviral IFN signaling, to negatively regulate antiviral innate immunity. PMID: 25311841
- highlight the role that VAMP3 and VAMP7 play in selection of the pathways leading to generation of ultrastructurally different LC3 compartments PMID: 25046114
- Patients with strong immunoreactivity to BECLIN 1 or LC3 had a significantly better overall survival (OS) than patients with negative to moderate immunoreactivity (p = 0.036 and 0.018, respectively). PMID: 25871810
- A significant association of LC3 expression with disease progression including a large tumor size, higher stage, and worse prognosis of hepatocellular carcinoma. PMID: 25005847
- high level of expression of BECLIN 1 and LC3 in tumours is well correlated with the overall survival of the patients. PMID: 25136588
- Results show that acetylation-deacetylation cycle ensures that LC3 effectively redistributes in an activated form from nucleus to cytoplasm, where it plays a central role in autophagy. PMID: 25601754
顯示更多
收起更多
-
亞細(xì)胞定位:Cytoplasm, cytoskeleton. Endomembrane system; Lipid-anchor. Cytoplasmic vesicle, autophagosome membrane; Lipid-anchor. Cytoplasmic vesicle, autophagosome. Note=LC3-II binds to the autophagic membranes.
-
蛋白家族:ATG8 family
-
組織特異性:Most abundant in heart, brain, liver, skeletal muscle and testis but absent in thymus and peripheral blood leukocytes.
-
數(shù)據(jù)庫鏈接:
Most popular with customers
-
-
YWHAB Recombinant Monoclonal Antibody
Applications: ELISA, WB, IHC, IF, FC
Species Reactivity: Human, Mouse, Rat
-
Phospho-YAP1 (S127) Recombinant Monoclonal Antibody
Applications: ELISA, WB, IHC
Species Reactivity: Human
-
-
-
-
-